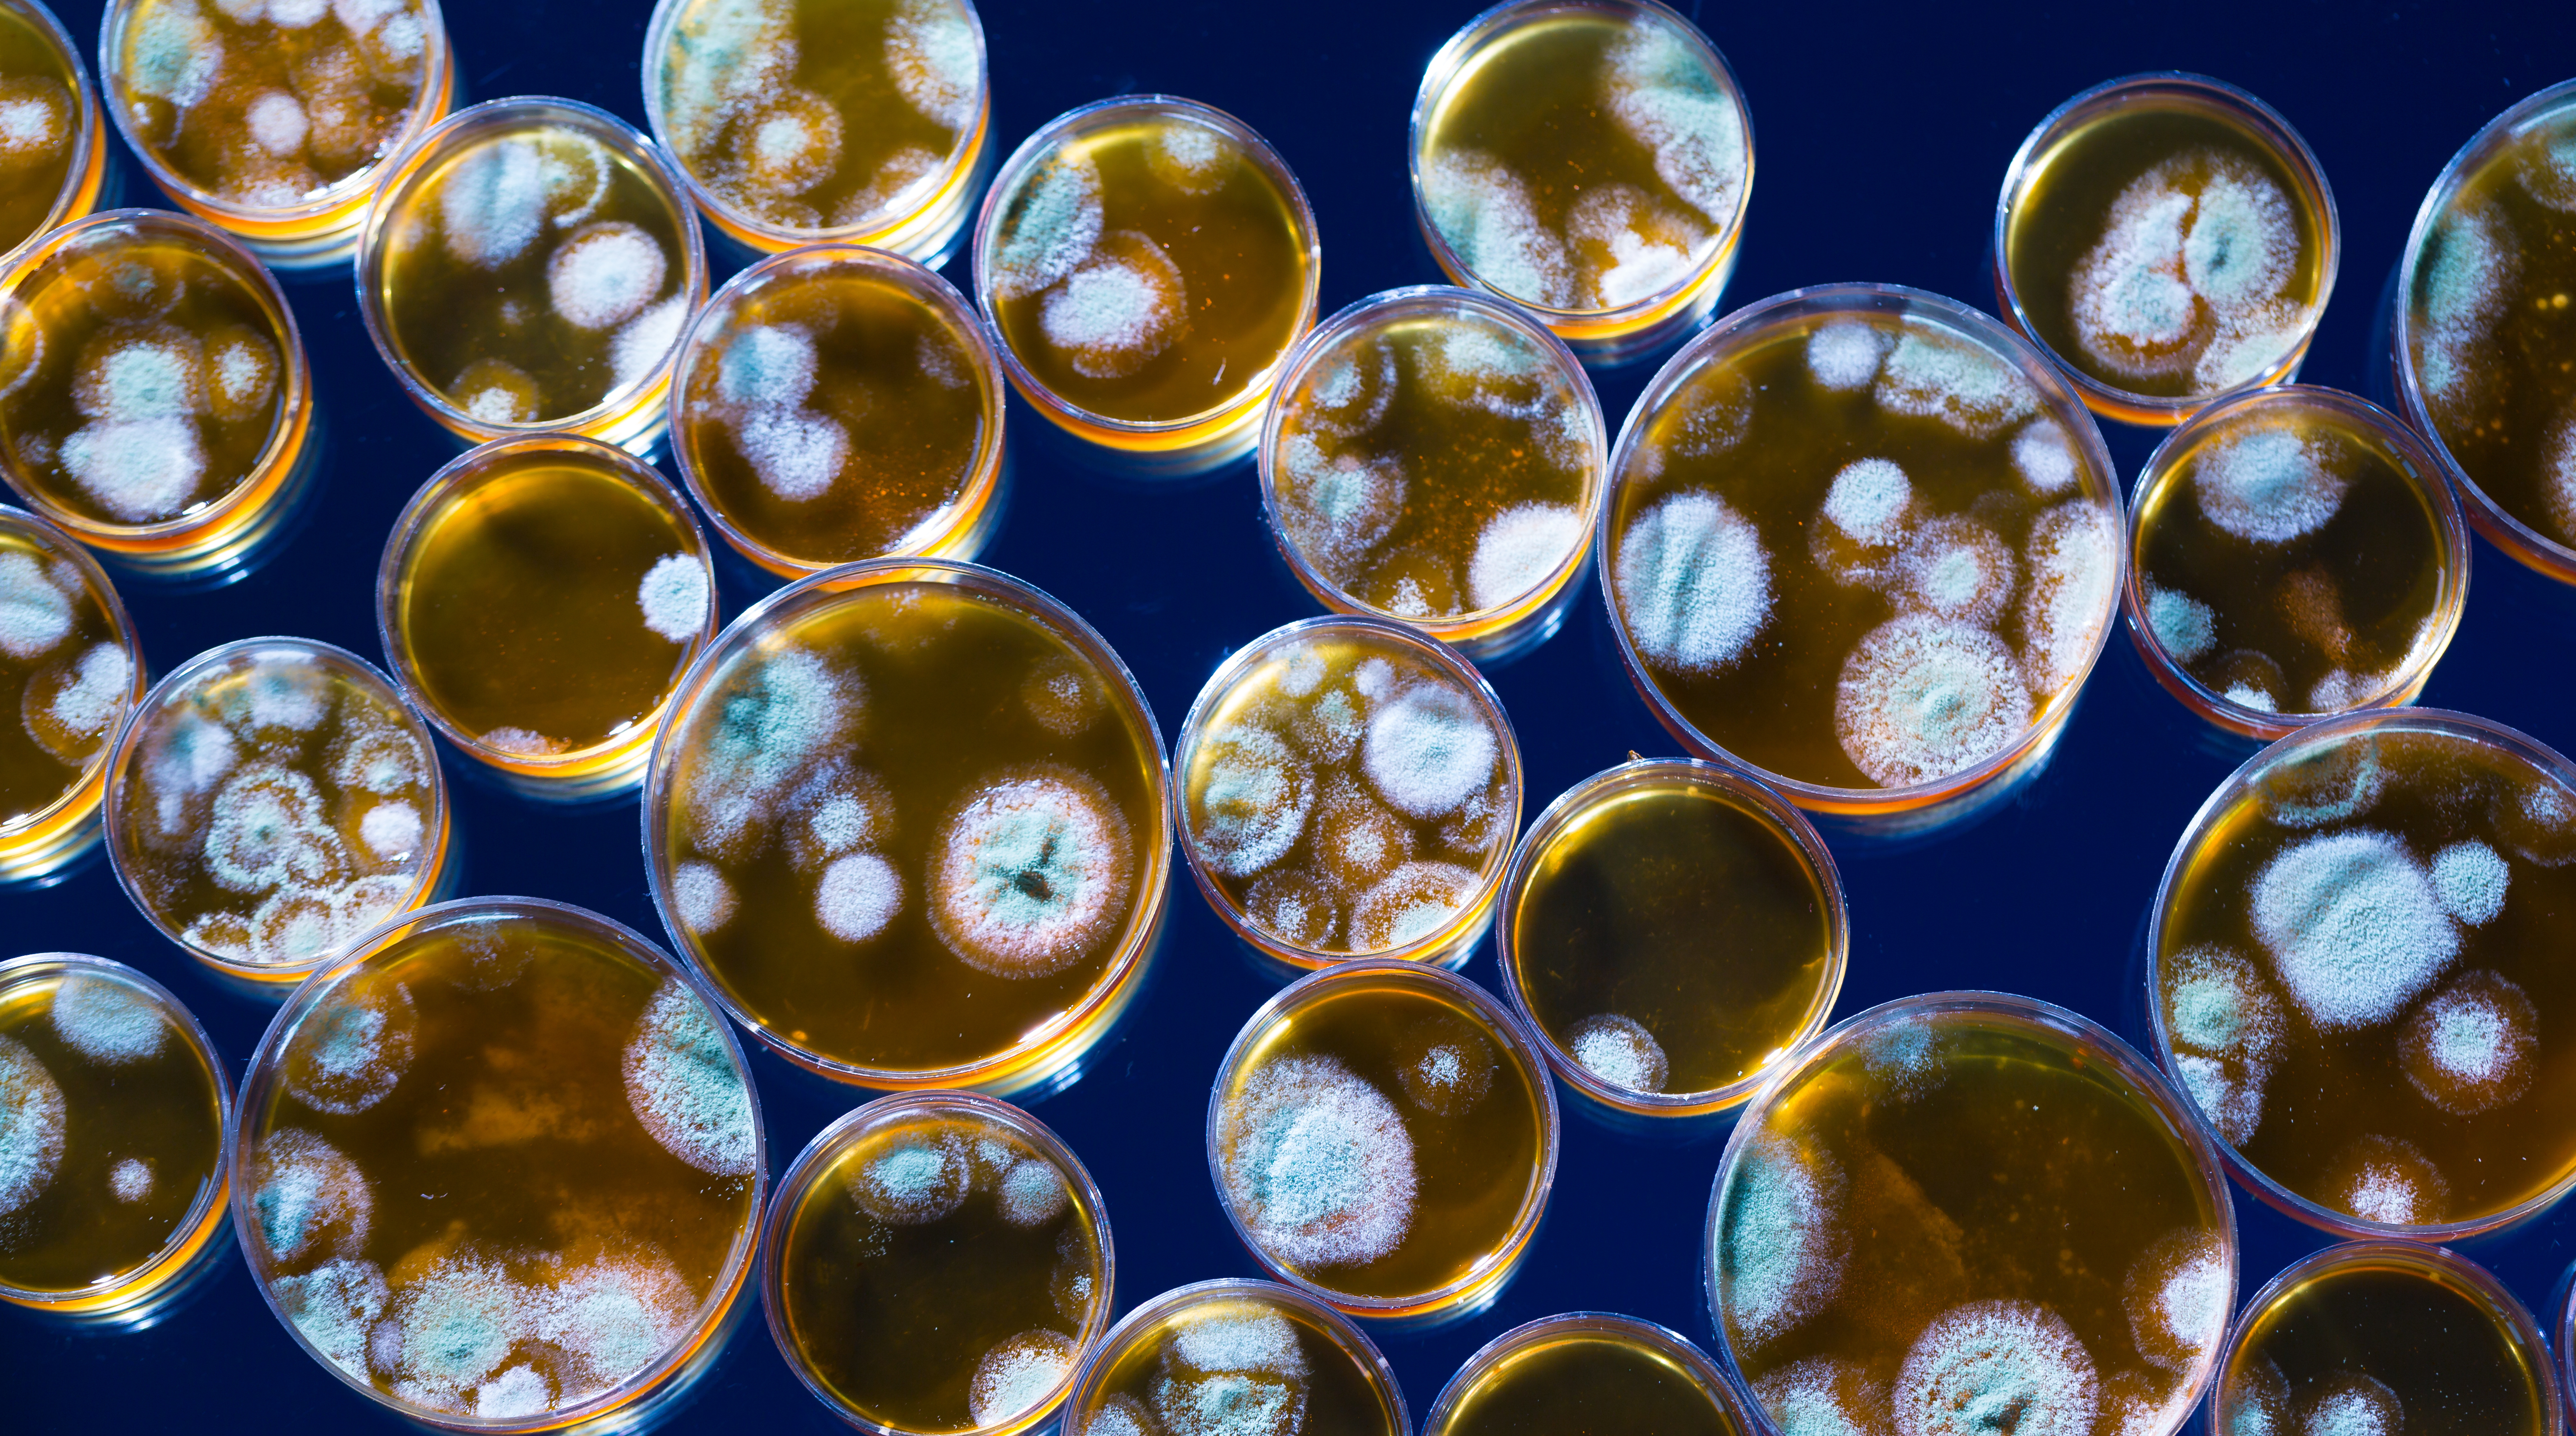

新入荷
再入荷
千聖 CHISATO CYBER ROSE〔English version〕 - YouTube
 タイムセール
タイムセール
終了まで
00
00
00
999円以上お買上げで送料無料(※)
999円以上お買上げで代引き手数料無料
999円以上お買上げで代引き手数料無料
通販と店舗では販売価格や税表示が異なる場合がございます。また店頭ではすでに品切れの場合もございます。予めご了承ください。
商品詳細情報
| 管理番号 |
新品 :7063010583
中古 :7063010583-1 |
メーカー | 198604042bf543 | 発売日 | 2025-05-21 11:17 | 定価 | 18400円 | ||
|---|---|---|---|---|---|---|---|---|---|
| カテゴリ | |||||||||
千聖 CHISATO CYBER ROSE〔English version〕 - YouTube
 千聖 CHISATO CYBER ROSE〔English version〕 - YouTube,
千聖 CHISATO CYBER ROSE〔English version〕 - YouTube, PENICILLIN・千聖 ソロデビュー20周年ベスト盤ジャケットで“20年前のアレ”を装着 | SPICE - エンタメ特化型情報メディア スパイス,
PENICILLIN・千聖 ソロデビュー20周年ベスト盤ジャケットで“20年前のアレ”を装着 | SPICE - エンタメ特化型情報メディア スパイス, 75th anniversary of first Penicillin treatment commemorated | University of Oxford,
75th anniversary of first Penicillin treatment commemorated | University of Oxford, 2025年最新】Yahoo!オークション -ペニシリン 千聖(音楽)の中古品・新品・未使用品一覧,
2025年最新】Yahoo!オークション -ペニシリン 千聖(音楽)の中古品・新品・未使用品一覧, 2025年最新】Yahoo!オークション -penicillin 千聖の中古品・新品・未使用品一覧,
2025年最新】Yahoo!オークション -penicillin 千聖の中古品・新品・未使用品一覧,



























